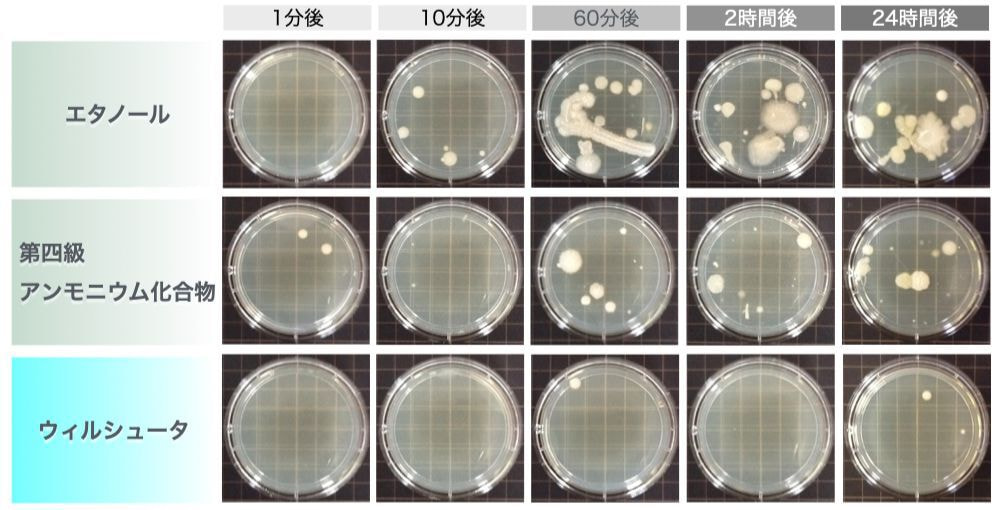

GZ-08・Virus Shooter
天然由来成分から生まれた除菌抗菌剤
GZ-08・ウィルシュータ シリーズ
独自技術による作用でウィルスや菌を不活化させ、消臭効果も
もたらす今までにない新しい除菌抗菌剤。
「除菌抗菌」と「人のカラダへの安全性」さらに「消臭効果」
を同時に叶えます!

天然由来成分から生まれた除菌抗菌剤
§ GZ-08・ウィルシュータの特徴
「安全性」と「効果」の両立、そして「持続」
✅ 強力で幅広い抗菌力 | 病原性の高い菌やウイルス、耐性菌、芽胞菌に対して広範囲に力を発揮します。 |
---|---|
✅ ニオイ菌も速やかに不活性化 | 医療機関・施設に特有の様々なニオイに対して効率よく作用します。 |
✅ しっかり安定し持続 | 空気や光、熱、有機物の影響を受けずに効果が続きます。 長期保存にも耐え、災害時の備蓄用としても役立ちます。 |
✅ 多岐の分野で国内外で活躍 | 医療福祉の現場の他、育児、食品、ペット業界などでも採用されています。 |
✅ 高い安全性 | アルコールや有害な成分を使用していませんので、アレルギーの心配がありません。 安全で、大変扱いやすい抗菌剤です。 |
§ 強力な抗菌性と持続性
GZ-08・ウィルシュータは、肌細胞を守りながら強力な除菌効果を発揮します。
さらに、その効果は、乾いた後も安全を保ちながら長く続きます。
§ GZ-08・ウィルシュータの消臭効果
GZ-08・ウィルシュータは、除菌・抗菌と同時に消臭力も発揮します。
持続性があり、一度消えたニオイが戻ることがありません。
成 分 | イメージ | 初期ガス濃度 | 10分後 | 30分後 |
アンモニア | 尿臭・疲労臭 | 100ppm | < 1ppm | ー |
トリルメチルアミン | 刺激性の魚臭 | 20ppm | < 1ppm | ー |
イソ吉草酸 | 足臭い・加齢臭 | 25ppm | 1.5ppm | < 1ppm |
酢酸 | 酢 | 10ppm | 2ppm | < 1ppm |
対象菌 | 試験種類(陰性確認) | 試験実施機関 |
黄色ブドウ球菌 | MBC測定 | (財)北里環境科学センター |
大腸菌 | MBC測定 | (財)北里環境科学センター |
カンピロバクター | MBC測定 | (財)北里環境科学センター |
緑膿菌 | MBC測定 | (財)北里環境科学センター |
クロストリジウム ウェルシュ菌 | MBC測定 | (財)北里環境科学センター |
肺炎桿菌 | MBC測定 | (財)北里環境科学センター |
メタロβラクタマーゼ産生菌 | MBC測定 | (財)北里環境科学センター |
MRSA(メチシリン耐性黄色ブドウ球菌) | MBC測定 | (財)北里環境科学センター |
MDRP(多剤耐性緑膿菌) | MBC測定 | (財)北里環境科学センター |
MDRA(多剤耐性アシネドバクター) | MBC測定 | (財)北里環境科学センター |
VRE(バンコマイシン耐性腸球菌) | MIC測定 | (財)北里環境科学センター |
クロストリジウム ディフィシル菌(芽胞) | MIC測定 | (財)北里環境科学センター |
セレウス菌 | MIC測定 | (財)北里環境科学センター |
対象ウイルス | 試験種類 | 感染価低下率 | 試験実施機関 |
ネコカリシウイルス | 抗ウイルス効果(3分) | <94.079% | (財)北里環境科学センター |
A型インフルエンザ(H1N1) | 抗ウイルス効果(15秒) | <99.99839% | (財)北里環境科学センター |
鳥インフルエンザ(H5N1) | 抗ウイルス効果 | <99.9997% | 鳥取大学農学部附属鳥由来 人獣共通感染症疫学研究センター |
鳥インフルエンザ(H5N1亜型) | 抗ウイルス効果(10分) | <99.99999% | (独)農業・食品産業技術総合研究機構 動物衛生研究所 |
抗ウイルス効果(10分) (有機物10%存在下) |
<99.99999% | ||
抗ウイルス効果 (1ヶ月乾燥後) |
<99.99999% | ||
鳥インフルエンザ(H7N7) | 抗ウイルス効果 | >99.99% | 京都産業大学先端科学技術研究所 鳥インフルエンザ研究センター |
ネココロナウイルス | ウイルス不活化試験 (10分) |
>99.99% | (財)北里環境科学センター |
新型コロナウイルス(SARS-CoV-2) | ウイルス不活化試験 (10分) |
検出限界以下 | 滋賀医科大学 病理学講座 疾患制御病態学部門 |
🔵ノンアルコール・無香料
対象菌 | 試験種類 (陰性確認) |
試験実施機関 |
黄色ブドウ球菌 | MBC測定 | (財)北里環境科学センター |
大腸菌 | MBC測定 | (財)北里環境科学センター |
カンピロバクター | MBC測定 | (財)北里環境科学センター |
緑膿菌 | MBC測定 | (財)北里環境科学センター |
クロストリジウム ウェルシュ菌 | MBC測定 | (財)北里環境科学センター |
肺炎桿菌 | MBC測定 | (財)北里環境科学センター |
メタロβラクタマーゼ産生菌 | MBC測定 | (財)北里環境科学センター |
MRSA (メチシリン耐性黄色ブドウ球菌) |
MBC測定 | (財)北里環境科学センター |
MDRP(多剤耐性緑膿菌) | MBC測定 | (財)北里環境科学センター |
MDRA (多剤耐性アシネドバクター) |
MBC測定 | (財)北里環境科学センター |
VRE (バンコマイシン耐性腸球菌) |
MIC測定 | (財)北里環境科学センター |
クロストリジウム ディフィシル菌 (芽胞) |
MIC測定 | (財)北里環境科学センター |
セレウス菌 | MIC測定 | (財)北里環境科学センター |
対象ウイルス | 試験種類 | 感染価 低下率 |
試験実施機関 |
ネコカリシウイルス | 抗ウイルス効果 (3分) |
<94.079% | (財)北里環境科学センター |
A型インフルエンザ (H1N1) |
抗ウイルス効果 (15秒) |
<99.99839% | (財)北里環境科学センター |
鳥インフルエンザ (H5N1) |
抗ウイルス効果 | <99.9997% | 鳥取大学農学部附属鳥由来 人獣共通感染症疫学研究センター |
鳥インフルエンザ (H5N1亜型) |
抗ウイルス効果 (10分) |
<99.99999% | (独)農業•食品産業技術総合研究 機構 動物衛生研究所 |
抗ウイルス効果 (10分) (有機物10%存在下) |
<99.99999% | ||
抗ウイルス効果 (1ヶ月乾燥後) |
<99.99999% | ||
鳥インフルエンザ (H7N7) |
抗ウイルス効果 | >99.99% | 京都産業大学先端科学技術研究所 鳥インフルエンザ研究センター |
ネココロナウイルス | ウイルス不活化試験 (10分) |
>99.99% | (財)北里環境科学センター |
新型コロナウイルス (SARS-CoV-2) |
ウイルス不活化試験 (10分) |
検出限界以下 | 滋賀医科大学 病理学講座 疾患制御病態学部門 |
🔵ノンアルコール・無香料
商品ラインナップ
🔹ウィルシュータ除菌消臭液(スプレー)
食品添加物由来成分で人体に極めて安全な消臭液です。
効果が長期に持続します。カーテンやリネン類、
ナースシューズ、オムツ交換時、トイレ消臭などに。

品 名 | 50mlスプレー |
---|---|
サイズ(㎝) | ボトル高さ 10.9 |
数 | 1本 |
Janコード | 4560277060221 |

500mlスプレー
品 名 | 500mlスプレー |
---|---|
サイズ(㎝) | ボトル高さ 22.7 |
数 | 1本 |
Janコード | 4560277060214 |

詰替え用5Lボトル
品 名 | 詰替用5Lボトル |
---|---|
サイズ(㎝) | 19.5×13.5×29.0(幅×奥行×高さ) |
数 | 1本 |
Janコード | 4560277060238 |

詰替え用20Lテナーボックス
品 名 | 詰替用20Lテナーボックス |
---|---|
サイズ(㎝) | 30.0×30.0×30.0(幅×奥行×高さ) |
数 | 1箱 |
Janコード | 4560277060245 |
🔹GZ-08ウィルシュータ感染新型対策スプレー
・人体や動物に必要なミネラルでマスクや手指をコーティング
・薬剤や毒物は一切不使用
・ハラール認証を取得
・マスクには優れた消臭効果も発揮
・アルコール(エタノール)消毒液との相性も大変よい抗菌液です
※持続型ですが、汗、接触、手洗いなどで徐々に成分は落ちます

GZ-08ウィルシュータ感染新型対策スプレー
品 名 | GZ-08ウィルシュータ感染新型対策スプレー |
---|---|
成分 | 水、金属イオン系除菌抗菌成分(無機物・国産)、 消臭成分(国産)、保存料(天然植物由来) |
内容量 | 50ml (約200回の噴霧) |
Janコード | 4560277069989 |
🔹ウィルシュータウェットタオル
肌荒れやベタつき、ニオイもなく、寒い時には温めて使えます。
手指や皮膚の清拭、備品の除菌、環境整備品として、
どなたにでもお使いいただけます。

ウィルシュータ ウェットタオル
500枚入りバケツ
(布タイプ:プレーン)
品 名 | ウィルシュータ ウェットタオル500枚入りバケツ |
---|---|
サイズ(タオル) | 15×30㎝ |
布タイプ | プレーン |
材 質 | レーヨン、ポリエステル |
数 | ・1個 ・4個/箱 |
Janコード | ・1個:4560277060238 ・4個:4560277060122 |

ウィルシュータ ウェットタオル
500枚詰替え用
(布タイプ:プレーン)
品 名 | ウェットタオル500枚詰替え用 |
---|---|
サイズ(タオル) | 15×30㎝ |
布タイプ | プレーン |
材 質 | レーヨン、ポリエステル |
数 | 1個 4個/箱 |
Janコード | 1個:4560277060139 4個:4560277060146 |

ウィルシュータ ウェットタオル
300枚入りバケツ
(布タイプ:プレーン)
品 名 | ウィルシュータ ウェットタオル300枚入りバケツ |
---|---|
サイズ(タオル) | 18×20㎝ |
布タイプ | プレーン |
材 質 | レーヨン、ポリエステル |
数 | ・1個 ・6個/箱 |
Janコード | ・1個:4560277060153 ・6個:4560277060160 |

ウィルシュータ ウェットタオル
300枚詰替え用
(布タイプ:プレーン)
品 名 | ウェットタオル300枚詰替え用 |
---|---|
サイズ(タオル) | 18×20㎝ |
布タイプ | プレーン |
材 質 | レーヨン、ポリエステル |
数 | 1個 6個/箱 |
Janコード | 1個:4560277060177 6個:4560277060184 |

110枚アルミパウチ
(布タイプ:メッシュ)
品 名 | 110枚アルミパウチ |
---|---|
サイズ(タオル) | 18×20㎝ |
布タイプ | メッシュ |
材 質 | レーヨン、ポリエステル |
数 | 1個 35個/箱 |
Janコード | 1個:4560277060191 35個:4560277060207 |
🔹ウィルシュータ防災・非常用ウェットタオル
災害時の衛生管理に役立ちます。
保存期限:未開封で5年。
【防災製品等推奨品マーク】取得

300枚バケツ
(布タイプ:プレーン)
品 名 | 300枚バケツ |
---|---|
サイズ(タオル) | 15×30㎝ |
布タイプ | プレーン |
材 質 | レーヨン、ポリエステル |
数 | 1個 |
Janコード | 1個:4560277060320 |

110枚アルミパウチ
(布タイプ:メッシュ)
品 名 | 110枚アルミパウチ |
---|---|
サイズ(タオル) | 18×20㎝ |
布タイプ | メッシュ |
材 質 | レーヨン、ポリエステル |
数 | 1個 |
Janコード | 1個:4560277060344 |
Contact us
お問い合わせ
【問い合わせ電話番号】
お電話でのお問い合わせはこちらから
0749-25-1393(滋賀本社)
03-5842-3301(東京支店)